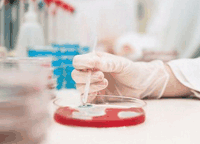

导读:只需抽取1毫升的血液,对于小于2公分的早期肝癌诊断准确率高约90%。记者29日从复旦大学附属中山医院获悉,我国医务人员发现了一种迄今为止特异性、敏感性和可操作性综合优势最为明显的肝癌诊断新方法。有望改变目前肝癌筛查传统方法,大大促进肝癌早发现、早诊疗,提高患者生存率。

肝癌起病隐匿,超过60%的肝癌患者在初次就诊时已经进入中晚期,从而失去根治性治疗的机会,总体5年生存率只有7%左右。目前临床上常用的肝癌诊断标记物为甲胎蛋白。然而,甲胎蛋白诊断肝癌的敏感度和特异度并不十分理想。复旦大学附属中山医院肝癌研究所科研团队与复旦大学病理系合作,经过3年攻关,终于在肝癌患者血浆中筛选到了由7个微小核糖核酸(microRNA)组成的早期肝癌诊断分子标记物。对于小于2公分的肝癌诊断准确率接近90%,对于甲胎蛋白隐性的肝癌的诊断正确率高达88%。

血常规检查项目及其意义

血液可以用来检测疾病,这早就不是什么新鲜事了,血液常规检查也已经为我们所用了数十年。但是近年来,人们仍然一直致力于研究血液中的各种成分,以期可以用血液来检测出更多的疾病。下面为大家介绍几项最新的用血液检测疾病的研究。
一项名为“致聋基因筛查”的新技术,近日由中关村企业博奥生物有限公司成功研发。筛查过程很简单,取几滴血液滴在指甲大小的生物芯片上,6小时后就能找出致聋基因。这张用于检测遗传性耳聋的基因芯片,是全球第一张用于临床的致聋基因检测芯片。
日本田中贵金属工业公司日前发表新闻公报说,该企业研制出一种利用金微粒高精度诊断前列腺癌的试笔。只要借助一两滴血液,就能在15分钟内判断血样提供者是否患有前列腺癌。
公报指出,这种试笔可以高精度检测出作为前列腺癌肿瘤标志的前列腺特异性抗原,从而为早期诊断作出贡献。在研制过程中,研发人员改良了用于迅速诊断流感抗原的胶体金免疫层析法,利用与金微粒结合的抗体和血中前列腺特异性抗原的反应,检测后者的水平。如果该抗原水平超标,试笔内的试纸上会出现红线。
抑郁症是现代人一种常见的精神疾病。多数患者都是在出现心情抑郁和意志消沉等症状时才去医院就诊,也往往靠医生根据患者症状和自身经验主观诊断。日本研究人员最新发现,通过检验血液的一项指标就能诊断抑郁症。研究报告说,血液中脑源性神经营养因子基因的甲基化程度能够作为诊断抑郁症的指标。新发现将有助于开发出一种像血糖或血压值那样科学、客观诊断抑郁症的方法,并开发出治疗药物。
研究结果不仅在一定程度上揭示了食管癌遗传的分子基础,同时也提示了高易感人群身上所携带的一种分子标记,利用这种标记,通过一滴外周血的检查就可能识别这种高风险人群,然后进行针对性的检查,随访。例如胃镜检查等,这样就可能有助于发现早期食管癌患者,从而做出准确的早期诊断,对高危人群进行筛查。

血液除了可以检测疾病以外,科学家们还发现,血液检测还可以有一些神奇的用途。
滴血认“清” 母血透露胎儿性别
电视里古代人民滴血认亲的场景总是不免让偶长吁短叹──这么简陋的方法得毁了多少和睦家庭啊!不过现代科学技术再次重温旧梦,科学家们通过检测不小心“漂入”母亲血液的胎儿DNA分子,可以准确预测baby的性别。【更多…】
荷兰开发出滴血知年龄技术
据英国《每日电讯报》和英国广播公司近日报道,荷兰科学家在《当代生物学》杂志网络版发表论文指出,他们研发出了一种滴血知年龄的技术:只要取得一滴血样,就可以分析出取样对象的大致年龄,误差范围在9年之内。
研究人员表示,这项新的鉴定技术适用于很多犯罪现场,只要有血迹存在,即使这些血迹有几十年的历史,也许就能帮助警方破获某些无头案或者陈年案找到蛛丝马迹。【更多…】